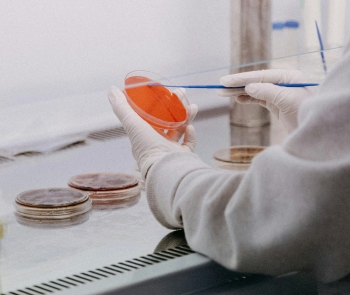

El Fons Lidera Tecnologies Avançades està orientat a impulsar projectes de transferència tecnològica sorgits d’universitats i centres de recerca de Catalunya. Inverteix des de les fases més inicials i acompanyat en rondes de finançament posteriors amb l’objectiu de facilitar el desenvolupament tecnològic, la valorització de la propietat intel·lectual i la creació i creixement de noves empreses basades en tecnologies avançades.
Centra el seu focus d’inversió en grans tendències tecnològiques amb alt potencial de creixement i impacte estructural, especialment en sostenibilitat, tecnologies habilitadores clau i medtech. El fons aposta per solucions que transformen el sector energètic, com l’emmagatzematge, la producció i distribució d’energia, el reciclatge, els bioplàstics, la captura de CO2 o l’hidrogen verd, així com per tecnologies profundes com la fotònica, la nanoelectrònica, el quantum, l’IoT, la robòtica, els nous materials, la impressió 3D i la intel·ligència artificial.
Paral·lelament, el fons inverteix en innovació mèdica orientada a la prevenció, diagnòstic, monitoratge, tractament i cura, amb una estratègia que combina companyies en fases inicials amb altres en etapes més madures, capaces d’atreure capital posterior i generar sortides rellevants.